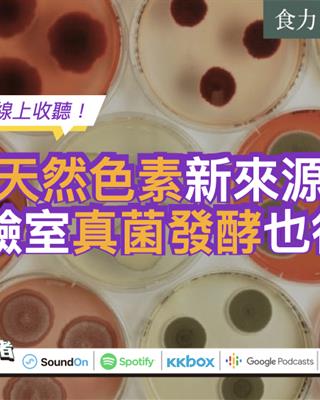

你應該要知道的食事
食品加工已有好幾百年的歷史,不同的加工技術有助於食物保存並延緩腐敗。
撰文=謝淨淳、許芷寧、朱逸瑄、蘇南維(國立臺灣大學農業化學系)
食品加工至今其實已經有好幾百年的歷史,透過加工我們可以確保食品的安全。不同的加工技術與作法能幫助延長食物的保存期限延緩腐敗,也讓消費者可以購買季節限定食品。而加工技術與方法相當多樣,但你究竟認識哪些加工方式呢?加工技術主要可以分為傳統加工技術和新興的加工方式,在本文中將一一帶你來認識加工技術對於食品的影響與其優勢。
傳統方法依然持續使用
1.加熱
加熱可以抑制病菌的生長、使酵素失去活性或殺死細菌。傳統的濕式加熱方法包含殺菁、沸騰、蒸煮以及高壓烹煮;乾式加熱則包含烘焙、油炸、燒烤。
而新興技術,則是利用電磁輻射如微波來進行。
另一個加熱技術-超高溫技術(UHT)在食品工業廣泛應用,透過135 度C加熱1秒鐘以上,並快速冷卻來殺死所有微生物。而常見的巴斯德殺菌則是加熱至72 度C,以15秒鐘來殺死大部分食品病原菌後,再快速冷卻至5 度C。
2.冷卻
低溫可以使食品中的細菌減緩生長速度或酵素失去活性,傳統冷卻方法包含冷藏於約5度C或冷凍低於-18度C(商業冷凍甚至低於-196度C);儲藏的溫度越低,食品可以保存的時間越長。然而,劇烈的溫度改變或冷凍時間太長,可能會造成食品結構的破壞,導致營養大幅流失。
3.乾燥
乾燥是讓食品的水分含量低於細菌基本生存條件的含量,如酵素活性或生長條件等,因而使食品不易腐壞。乾燥方法則包含凍乾(如中草藥或咖啡)、噴霧乾燥(奶粉)、日曬乾燥(如番茄、杏仁)或隧道式乾燥(如:蔬菜)。
4.鹽醃法
鹽醃法是使用好幾百年的保存方法,利用鹽巴減少食物的水活性,避免病源菌的生長,糖醃也是利用同樣原理來保存;加酸(醋)來改變食品的pH同樣可抑制或殺死某些病原菌。
一般鹽醃法是指用乾鹽來保存,經常用於保存肉品,將鹽直接塗抹在肉的表面,例如義大利帕爾瑪火腿便是利用此原理製成的。另一種方法則是浸泡鹽液或是酸性液體(浸酸法)。將食物浸泡於飽和食鹽水普遍用在保存肉品和蔬菜,雖此方法現今較不普遍,但仍應用於起司如羊奶起司或哈羅米起司的熟成。
浸酸法則是添加醋或結合發酵以保存蔬菜及魚肉,例如:酸菜、黃瓜、胡椒、洋蔥、橄欖和鯡魚,醃製通常利用鹽與糖,有時會添加硝酸鹽或亞硝酸鹽來抑制肉毒桿菌的生長,並作為保色劑。
5.發酵
挑選特定酵母菌或細菌進行發酵除了使食物有特殊風味和口感,還能改變食物的生物活性,避免致病菌的生長。
酵母菌最常使用於麵包發酵和酒精飲料的製作,而醬油也是一種酵母發酵製品。在有氧環境下,酵母菌會將糖或其他碳水化合物轉成二氧化碳和水,所以麵團才會膨脹,烘烤過後,麵團的海綿構造固定後,即有鬆軟的口感,酵母菌則在加熱後死亡。酵母在啤酒、葡萄酒以及其他酒精飲料功能是產生酒精,或是二氧化碳。在無氧的條件下,酵母菌會將糖或其他碳水化合物轉成酒精和二氧化碳,使飲料有氣泡感。一般發酵製程是加入特定酵母菌培養物來進行,但有些發酵飲料是自發性發酵,意指由酵母菌和其他微生物在葡萄或其他環境之下自然進行發酵。麵團發酵過程中,因為消耗掉氧氣,使得環境從有氧轉為無氧環境,雖然會產生酒精,但烘烤過後,酒精揮發,因此麵包中不含酒精。啤酒和葡萄酒方面,發酵是產生特殊味道的重要因素,除了酒精和二氧化碳,發酵還會產生其他化合物來增添風味。
另一種常用於食品發酵的是乳酸菌發酵。乳酸菌利用乳糖或其他碳水化合物發酵產生乳酸,當產生的乳酸累積越多,食品中的pH值下降,使得對酸敏感性的蛋白質變性,例如牛奶中的酪蛋白,在乳酸發酵後,酪蛋白會凝集,牛奶變稠厚,可以製成優格和其他乳製品;其他如酸菜、泡菜、酸麵包和義大利蒜味臘腸也都是乳酸發酵製品。
如上述之介紹,發酵產生的酒精和酸度可以抑制微生物的生長與繁殖,延長食品的保存期限。食物中無害的微生物會和其他有害微生物競爭有限營養源,因此數量受到病原菌所影響。
除了味道、口感、質地和安全性,發酵也可增加食品的營養價值。微生物發酵過程會產出胺基酸、脂肪酸和某些維他命等人體容易吸收的小分子,或是降低干擾人體吸收的抗營養物質。其中一例為酸麵包,內含乳酸菌,具有消除植酸鹽的效用。植酸鹽為一種存在全麥麵粉的抗營養素,會和礦物質形成錯合物,導致小腸吸收鈣、鐵、鋅、鎂離子的能力降低,因此酸麵包裡的微生物可利用的礦物質含量比較高。
新興科技讓營養更完整保留
傳統的保存加工方法大都無可避免一些養分流失,因此目前的技術致力於在不降低品質的前提下,使的營養流失降到最少,甚至提高美味程度。
1.微波
與傳統的熱對流或熱傳導方式不同,微波是利用熱輻射原理進行加熱。微波在水裡具有很好的穿透性,但在塑膠和玻璃上效果較差,也會被金屬反射。藉由食品中的水分子震動摩擦產生熱,但是食品中的水分分布不均勻,所以需要適時地攪拌使熱源分布均勻。微波食品是一種只需要添加少量的水即可快速加熱的方法,因此可減少烹調時營養素的流失。
2.調氣包裝
調氣包裝是改變包裝內的氣體組成來控制食物的穩定性,同時也抑制細菌的生長,通常使用氧氣、二氧化碳和氮氣,另外調氣包裝也可為真空包裝或填氣包裝。近來的調氣包裝材料主要為活性包材,讓包裝裡的氣體在保存期限內可以不斷變化,例如,氧氣吸附劑或是排除二氧化碳膜,因為降低氧氣含量和增加二氧化碳含量而可以達到抑制微生物的生長的目的。
肉品和起司為不會進行呼吸作用的產品,因此需要極低氣體穿透度的膜材料來維持包裝內的氣體組成。換句話說,包裝材料和食品的交互作用對會進行呼吸作用的食物(如蔬果)是非常重要的,透過改變包裝內氣體能延長貨架期。
3.輻射
電離輻射是利用高能游離態粒子阻斷微生物的生化反應,達到延長貨架期的效果,除了用於食品上,也可用在包裝材料上;從生化反應的角度來看,包含抑制發芽、延緩熟成和防止病蟲害感染;由微生物的角度來看,能夠抑制病原菌的生長。整體而言,電離輻射最大的優點在於輻射可穿透食物來殺菌,而不會有加熱破壞營養的缺點,雖然蛋白質和碳水化合物可能會些微分解,但營養價值影響不大。
在歐洲食品法(1999/2/EC和1999/3/EC)當中,只有特定條件才可被授權使用電離輻射進行加工:
・必須有合理的技術需要
・沒有健康風險
・對消費者有益
・不可用於公共衛生或良好農作
此外,任何進行游離輻射的食品,需在成分標示上明確標示。
4.歐姆加熱
又稱為電阻加熱或是直接電阻加熱,透過交流電通過食品內部,為一種電阻產熱的熱處理方式,因為歐姆加熱不需仰賴水分子,因此很適合低水分和小顆粒的食品。歐姆加熱也是短時間高溫加熱方式的一種(HTST),可避免長時間高溫而使得養分流失,也可維持食品原本精緻的外觀,如草莓。
5.超高壓
將食品放在100~1000兆帕的壓力下5~20分鐘,除了可以使微生物失去活性外,因為不經加熱處理,只破壞非共價鍵結,所以能維持食品中維他命、色素和氣味等化合物。
6.脈衝光
此方法利用白光(20%UV,50%的可見光,30%的遠紅外線)以每秒1~20MHz快速閃爍,強度是太陽照射地球表面的2萬倍,能減少食品表面的微生物數量,目前應用於肉品和烘焙食品。此方法適用於具有光滑表面的食品及包裝材料的殺菌。
7.脈衝電場(PEF)
短時間內重複高壓電場(10~50 kV/cm)下,脈衝電場和脈衝磁場交互作用,破壞微生物的細胞膜使其釋出胞內物質而死亡,因為不使用熱處理,故不會影響熱敏感的營養物質;常應用於冷藏和室溫保存的食品。
食品加工技術之時間演進表:
延伸閱讀:
▶加工食品有其目的 非你想像的可怕
▶食品史上的4月20日 巴氏殺菌法完成首次測試
▶不加熱也可殺菌?日本電氣殺菌已應用在果汁、鮮乳
參考資料:
▶Eufic (2010) Food Production The Greatest Thing Since Sliced Bread? A Review of The Benefits of Processed Foods
▶Henry CJK & Chapman C. (2002). The nutrition handbook for food processors. Woodhead Publishing Ltd.
▶International Food Information Council (2009). From farm to fork: Questions and answers about modern food production.
▶MacEvilly C & Peltola K (2003). The effect of agronomy, storage, processing and cooking on bioactive substances in food. In Plants, Diet and Health Ed. Gail Goldberg. Blackwell Science Publishing.
▶Mills EN, et al. (2009). Impact of food processing on the structural and allergenic properties of food allergens. Molecular Nutrition & Food Research 53(8):963-969.
▶BNF (1999). Nutrition and Food Processing. British Nutrition Foundation Briefing Paper.
▶Paschke A (2009). Aspects of food processing and its effect on allergen structure. Molecular Nutrition & Food Research 53(8):959-962.